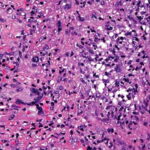

Contact Us :
👤 Users: 0 | 👁 Guests: 4 | 🌍 Total: 4
Atypical mycobacteria =المتفطرات اللا نموذجية
Atypical mycobacteria
pathologic examination of tissue can reveal tuberculoid, palisading, and sarcoidlike granulomas; a diffuse infiltrate of histiocytic foamy cells; acute and chronic panniculitis; nonspecific chronic inflammation; cutaneous abscesses; suppurative granulomas; and necrotizing folliculitis. Suppurative granulomas are the most characteristic feature in skin biopsy specimens from cutaneous atypical mycobacteria infections. The evolution of the disease and the immunologic status of the host may explain this spectrum of morphologic changes.
Some authorities note severe inflammatory lesions involved with the dermis and the hypodermis; these can have 3 main histopathologic patterns: granulomatous nodular or diffuse inflammation with mixed granulomas, prevailing abscesses with mild granulomatous reaction, and deep dermal and subcutaneous granulomatous inflammation with no neutrophil component.
Some authorities note severe inflammatory lesions involved with the dermis and the hypodermis; these can have 3 main histopathologic patterns: granulomatous nodular or diffuse inflammation with mixed granulomas, prevailing abscesses with mild granulomatous reaction, and deep dermal and subcutaneous granulomatous inflammation with no neutrophil component.